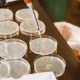

health-check domain was triggered too early. This is usually an indicator for some code in the plugin or theme running too early. Translations should be loaded at the init action or later. Please see Debugging in WordPress for more information. (This message was added in version 6.7.0.) in /nas/content/live/brownpelican/wp-includes/functions.php on line 6131mfn-opts domain was triggered too early. This is usually an indicator for some code in the plugin or theme running too early. Translations should be loaded at the init action or later. Please see Debugging in WordPress for more information. (This message was added in version 6.7.0.) in /nas/content/live/brownpelican/wp-includes/functions.php on line 6131

World’s largest wildlife crossing on track to open by early 2026. ... Governor Gavin Newsom today announced that the Wallis Annenberg Wildlife Crossing outside of Los Angeles is on track to open by early 2026. https://www.gov.ca.gov/2024/05/07/worlds-largest-wildlife-crossing-on-track-to-open-by-early-2026/
Nathanael Blake is a senior contributor to The Federalist and a fellow in the Life and Family Initiative at the Ethics and Public Policy Center. He is the author of “Victims of the Revolution: How Sexual Liberation Hurts Us All” (Ignatius, 2025).
At least the bombs are real.